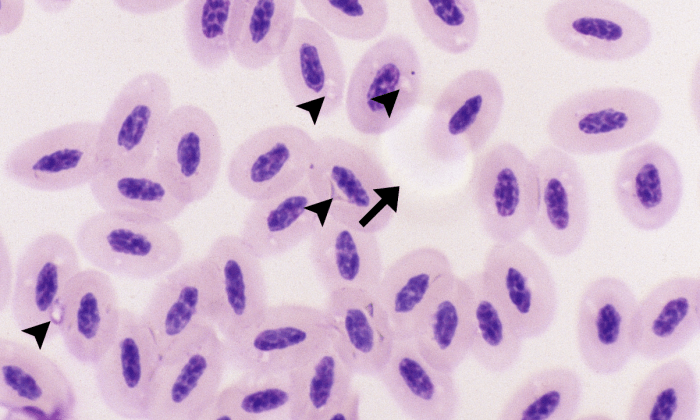
Normal Exotics 2 (Hawk 1 - Hemoproteus) ARROWS

Exotics

Avian: mature erythrocytes are oval cells with pink-orange cytoplasm and a dark blue nucleus located centrally. Immature erythrocytes have a round shape, a lighter blue nucleus, and light blue cytoplasm. Avian erythrocytes may show some variability in shape (oval, crenated, teardrop, or spindle-shaped). Small, irregular, clear spots near the nucleus are commonly observed in avian erythrocytes but have no pathologic significance.